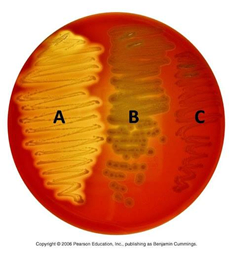

Streptococcus
이론과 하이라이트 히스토리를 확인 할 수 있어요.
Strepto-(사슬) + Coccus(알균). 현미경으로 관찰 시 사슬모양을 이루는 알균들이 보여 이름붙여졌다.
1. 개요
1) 그람양성 알균
2) Catalase 음성
2. 분류
1) 혈청학적으로 Lancfield 분류를 통해 알파벳으로 분류
2) 용혈 양상에 따라 α, β, γ로 분류
용혈형태 | 정의 | 색상 | 대표 균종 |
α | 불완전 용혈 | 녹색 | S. pneumoniae, Viridans streptococci |
β | 완전 용혈 | 투명 | S. pyogenes, S. agalactiae |
γ | 용혈 없음 | - | Enterococcus faecalis 등 |
3. 각론
1) S. pyogenes (Group A Streptococcus, GAS)
(1) β 용혈
(2) Group A
증상 | 화농성 | Non-invasive | 인두염, 농가진, 단독 |
Invasive | 성홍열, 괴사성 근막염, Streptococcal Toxic Shock Syndrome (STSS) | ||
비화농성 | (후유증) | 류마티스열 (Acute rheumatic fever), 사구체신염 (Post-Streptococcal Glomerulonephritis)* |
*소아에서 가장 흔한 acute nephritic syndrome. 대부분 Streptococcus가 원인균이다. 균 감염에 의해 생성된 항체가 면역복합체를 이루고, 혈액을 따라 돌다가 신장의 subendothelial space에 침착되어 손상을 일으키는 것이 기전이다. 균 감염시점으로부터 약 2주 정도의 잠복기를 거친 후 나타난다.
(3) 바시트라신 감수성을 띤다.
(4) Streptolysin S와 O를 분비한다. ASO(antistreptolysin O) 항체를 검출하여 GAS의 최근 감염을 확인할 수 있다.
2) S. agalactiae
(1) 약한 β 용혈, 때때로 비용혈
(2) S. aureus와 만나면 β 용혈 증폭 (CAMP Test)
(3) 여성 생식기에 normal flora로 존재한다.
(4) 신생아 패혈증, 뇌수막염의 대표적 원인 중 하나이다. (산도 감염)
3) S. pneumoniae
(1) α 용혈
(2) 옵토킨 감수성을 띤다.
(3) 뇌수막염의 3대 원인균 중 하나. 세균성 폐렴, 수막염, 중이염, 부비동염, 균혈증의 흔한 원인이다.
4) Viridans group Streptococcus
: Viridans’는 라틴어로 ‘녹색을 띠는’이라는 뜻으로, 혈액한천배지에서 녹색(α-용혈)의 집락을 형성하는 데서 유래하였다.
(1) α 용혈 또는 비용혈
(2) 구강의 normal flora.
(3) 대부분 기회감염(opportunistic infection)으로 발생하며, 대표적으로 감염성 심내막염 (Infective Endocarditis)을 일으킨다. 특히 치과 치료 이후 균혈증을 통해 생기는 심장판막 감염이 흔하다.